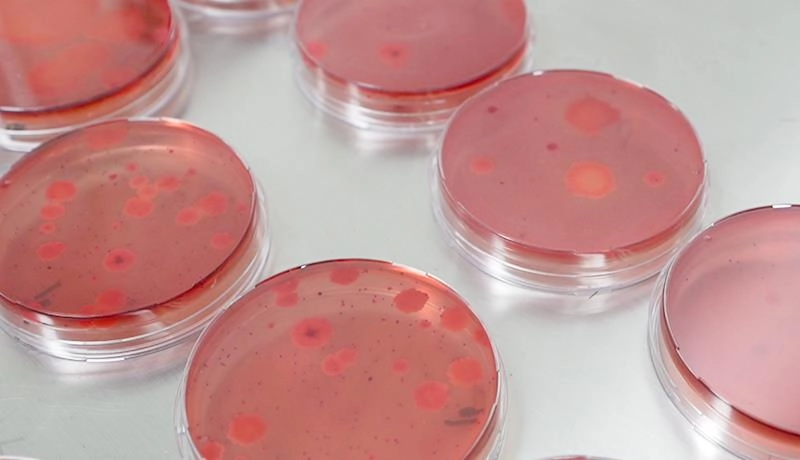
康德权

康德权 始于 1999
专业从事生物包膜饲料添加剂的研发、生产和市场推广拥有智能微囊包膜专利技术(IM技术),已成长为全球三大专业包膜企业之一,在业内素有“包膜专家”的美誉

视频播放
20余年专业包膜经验,拥有智能微囊包膜专利技术(IM技术)研发成果获得国家科技进步二等奖,包膜丁酸钠专利荣获第十九届中国专利奖复乳能专利技术荣获第二十一届中国专利奖国家高新技术企业...

-
28创新产品孵化中心
-
5000+技术服务客户
-
56市场覆盖国家
最新资讯
-
迎战无抗 如何多维重启饲养新模式?— —2020畜牧饲养技术论坛暨康丸德川新品发布会隆重举行随着7月1日“禁抗令”的全面实施,我国畜牧饲养面临新的挑战。畜牧业迫切需要找到新型饲养模式以适应无抗新时代。在此背景下,7月29日,康德权集团在杭州康德权总部隆重举办了“2020畜牧饲养技术论坛暨康丸德川新品发布会”。论坛围绕“如何多维重启新饲养?”话题展开分享与讨论。...公司新闻
 2020-07-13
2020-07-13
-
喜报丨杭州康德权饲料有限公司通过《知识产权合规管理体系》认证...公司新闻
 2026-04-29
2026-04-29
-
喜报丨杭州康德权饲料有限公司《半胱胺或其盐在制备预防和改善蛋鸡脂肪肝的饲料添加剂中的应用》荣获国家发明专利!...公司新闻
 2026-04-22
2026-04-22
研发创新
我们拥有省级重点企业研究院,与众多具有国际影响力的包膜技术应用和检测平台合作,立足包膜技术研发的高地
-

 IM智能微囊技术
IM智能微囊技术 IM智能微囊技术智能微囊技术(IM)是康德权包膜添加剂产品的核心技术,是使壁材均匀地覆盖在芯材的表面,形成质地均匀的微球(粒径可控范围在120~1800微米之间,10~120目)。微球在特定pH值、酶等的作用下,活性成分在动物体内缓释、控释或靶向释放,让活性成分发挥最佳的效能。
IM智能微囊技术智能微囊技术(IM)是康德权包膜添加剂产品的核心技术,是使壁材均匀地覆盖在芯材的表面,形成质地均匀的微球(粒径可控范围在120~1800微米之间,10~120目)。微球在特定pH值、酶等的作用下,活性成分在动物体内缓释、控释或靶向释放,让活性成分发挥最佳的效能。 -
微生物共生驯化技术
微生物共生驯化技术 微生物共生驯化技术筛选优势菌株,依托自有IBI研发平台,通过30余年特有的微生物驯化技术以及微生物复合培养技术,使微生物获得特定生理性能,且微生物群体间融合共生,减少冲突,让多种微生物协同发挥更优质的应用效果
微生物共生驯化技术筛选优势菌株,依托自有IBI研发平台,通过30余年特有的微生物驯化技术以及微生物复合培养技术,使微生物获得特定生理性能,且微生物群体间融合共生,减少冲突,让多种微生物协同发挥更优质的应用效果
-
50申请专利
-
400发表论文
-
46研发合作单位
-
80+研发包膜产品/年
-
300+检测包膜产品/年


-
 研发服务
研发服务 -
 技术定制服务
技术定制服务 -
 检测服务
检测服务













